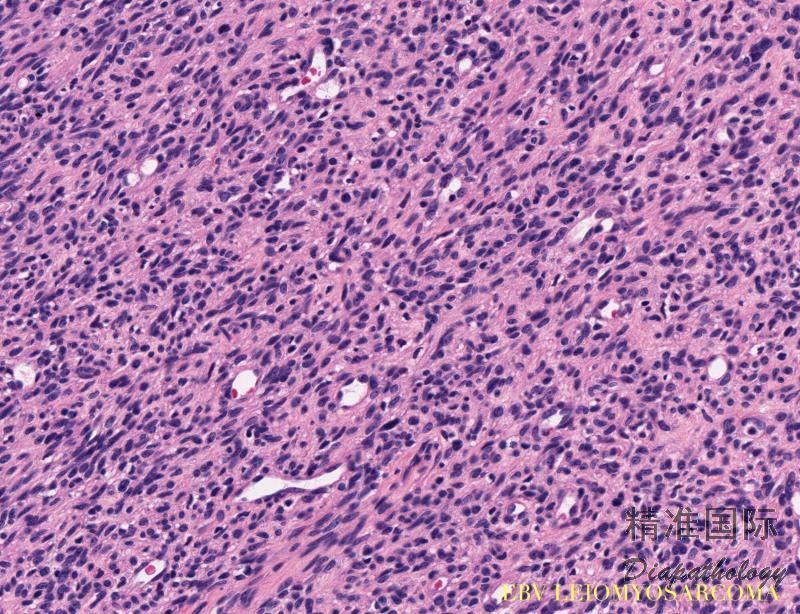

EBV 相关性平滑肌肉瘤
EBV-Associated Leiomyosarcomas
概述:
一种在肿瘤组织内可检测出 EBV 的平滑肌肉瘤,本病多发生于免疫抑制的儿童,也可见于受 HIV 感染的成人。
发病部位: 多发生于软组织和实质器官,如肺、肝、胃肠道、脾等。
诊断要点:
- 肿瘤多发生于软组织和实质器官,如肺、肝、胃肠道、脾等,少数位于颅内; 多见于免疫系统功能低下者,如器官移植,HIV 感染等;
- 大体检查肿瘤类似平滑肌瘤,质地偏硬,切面呈灰白色、漩涡状;
- 镜下见肿瘤由成束的梭形细胞组成,可呈交织状排列,从典型的平滑肌肉瘤到分化成熟的平滑肌细胞,瘤细胞异型性不显著,瘤细胞核分裂活跃,瘤组织见较多的淋巴细胞浸润(主要为 T 淋巴细胞);
- 免疫组化标记 EBV 病毒的潜伏膜性蛋白(latent membrane protein,LMP)和 EBV 表面受体蛋白 CD21 有一定的诊断价值;
- EBER 原位杂交检测阳性;
免疫组织化学染色:
所有病例 SMA 均阳性,约 50%可见 Desmin 阳性,亦常见 CD21 阳性。
鉴别诊断:
平滑肌瘤:子宫外内脏发生少见;形态学与 EBV 相关性平滑肌肉瘤大多数情况下不易区分;EBER 原位杂交阴性。
血管平滑肌瘤:常发生在软组织,内脏发生少见。
肌性血管周细胞瘤:好发于四肢软组织,内脏发生少见;瘤细胞主要围绕血管周围,瘤细胞较小。
预后:
较好。
治疗:
手术切除;化疗、放疗、抗病毒治疗的效果有待证实。
参考文献:
Jossen J et al: Epstein-Barr virus-associated smooth muscle tumors in children following solid organ transplantation: A review. Pediatr Transplant. 19(2):235-43, 2015
Hussein K et al: Clinico-pathological characteristics of different types of immunodeficiency-associated smooth muscle tumours. Eur J Cancer. 50(14):2417-24, 2014
Issarachaikul R et al: Epstein-Barr virus-associated smooth muscle tumors in AIDS patients: a largest case (series). Intern Med. 53(20):2391-6, 2014
← 腹膜播散性平滑肌瘤病 透明细胞肉瘤 →